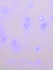
Светодиодная гирлянда Uniel бахрома (07950) синий ULD-B3010-200/DTA Blue IP20

Светодиодная гирлянда Uniel бахрома (07950) синий ULD-B3010-200/DTA Blue IP20
| Бренд | Uniel |
| Коллекция | Бахрома |
| Артикул | ULD-B3010-200/DTA Blue IP20 |
| Стиль | Современный |
Характеристики
| Бренд | Uniel |
| Коллекция | Бахрома |
| Артикул | ULD-B3010-200/DTA Blue IP20 |
| Стиль | Современный |
| Страна | Китай |
| Цвет арматуры | Прозрачный |
| Материал арматуры | Пластик |
| вид ламп | Светодиодная |
| цоколь | LED |
| напряжение | 220 |
| степень защиты (ip) | 20 |
| Гарантия | 18 месяцев |
| штрих-код (служебное) | 4690485051770 |
| коробка вес гр | 350 |
| коробка высота | 135 |
| коробка длина | 105 |
| коробка ширина | 90 |
| кратность | 1 |
| популярность | 999996208 |
| цвет свечения | Синий |
| Высота, мм | 700 |
| Длина, мм | 3000 |
| Мощность лампы, W | 9 |
| Общая мощность, W | 9 |
| Лампы в комплекте | Да |
Светодиодная гирлянда Uniel бахрома (07950) синий ULD-B3010-200/DTA Blue IP20 отзывы
Об этом товаре отзывов пока нет. Будьте первым!
Поделиться:
Другие товары коллекции